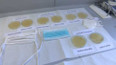
Školní experiment o účinnosti roušek

24. září 2020
Část: Dopravní nehody na D1
Obsah dílu
Omezení v restauracích a barech — Hospody musí zavřít v deset večer — Prognózy na další dny — Vývoj nákazy v Česku — Omezení při cestách do Německa — Rakousko omezuje cesty z Česka — Situace ve školách — Spor o nový návrh migračního paktu — KLDR zavraždila jihokorejského úředníka — Jednání o rozpočtu MPSV — Dopravní nehody na D1 — Trump odmítl říct, zda uzná případnou porážku — Výstava Remrandtových děl v Národní galerii — Násilné střety Black Lives Matter s policií — Zadržení v Bělorusku — Předpověď počasí na další dny — Sporná reklama v Praze — Trest za porušení karantény — Omezení hromadných akcí — Opatření na sportovních akcích — Omezení v podnicích — Kontaminace řeky Bečvy — Prodej bytů H-Systemu — Spory kvůli plynovodu NordStream 2 — Předvolební debaty ČT — Pieta za vyhnané z pohraničí po mnichovské dohodě — Dopravní uzavírky v Praze — Mimořádný příspěvek seniorům — Izrael zpřísňuje celostátní karanténu — Školní experiment o účinnosti roušek
Části dílu

Přehled dílů

2. listopadu
Headlines — Koaliční smlouva ANO, SPD a Motoristů — Přípravy nové koalice na vládu — Plány vznikající vlády — Vyjádření prezidenta k návrhu programového prohlášení vlády — Útok nožem ve vlaku v Británii — Trump pohrozil Nigérii — Dostavba Dukovan zvýší nároky na jadernou bezpečnost — Pomoc lidem po mrtvici — Bitva o Pokrovsk — Památka věrných zesnulých — Výsledky Cen Thálie — Vykolejení vlaku v Neratovicích — Liberalizace cen se v obchodech před 35 lety — Nová metoda léčby nádoru mozku — Zloději šperků z Louvru — Příčiny požárů komínů — Přísnější pravidla pro cestování s elektronikou — Příručka pro krizové situace — Krizové situace — Polská příručka pro přežití — Menší zájem o kluby a baryu mezi mladými lidmi — Oběti laviny v Jižním Tyrolsku — Vládní strategie k biodiverzitě — Demonstrace v Srbsku — Problémy ruské ekonomiky — Stavba metra D — Dopravní komplikace v okolí Prahy — Zájem o zvěřinu roste — 25 let obydlená ISS — Festival dokumentárních filmů v Jihlavě

2. listopadu
Znakový jazyk a skryté titulky

1. listopadu
Headlines — Vznikající vláda a rozpočet na příští rok — Plán na schválení rozpočtu — Program v oblasti dopravy — Dopravní omezení v pražské Uhřiněvsi — Připomínka obětí neštěstí v srbském Novém Sadu — Bitva o Pokrovsk — Pokročilá umělá inteligence trápí odborníky — Opravená ozubená trať v Jizerských horách — Zájem o německé firmy — Ceny Thálie — Předávání těl rukojmích — Růst spotřeby energie — Boj proti vandalismu — Nová expozice v ČNB — Sledování dětí v inkubátoru z domova — Nejstarší CHKO Český ráj si připomíná 70 let — Velké egyptské muzeum — Úklid spadaného listí — Žloutenka A se nadále šíří — Čekací doba na vakcíny proti žloutence A — Jak se žloutenka rozšířila — Následky hurikánu Melissa — Závěry summitu v Jižní Koreji — Výstava o péči, která inspiruje — Ekologičtější a dostupnější domy — Premiéra muzikálu Masaryk — Ochrana vzdušného prostoru NATO — Manželé z Francie chtějí přeplavat Atlantik — Na Ďáblickém hřbitově pátrají po ostatcích politických vězňů — Končí jihlavský filmový festival

1. listopadu
Znakový jazyk a skryté titulky

31. října
Headlines — Programové prohlášení vlády — Reakce politiků současné vlády — Programové priority vznikající koalice — Návrh poslala vznikající koalice Hradu — Detaily z návrhu programového prohlášení — Plány vznikající vlády k energetice — Shutdown v USA trvá už mesíc — Návrat těl rukojmích — Nový rektor Univerzity Karlovy — Ševčík kandiduje na rektora VŠE — Spoření a investice — Ruský útok na Sumy — Oběti ruské invaze na Ukrajině — Končí cestovní kancelář Travel Family — Fernando Krapp mi napsal dopis v Činoherním klubu — Diamo přebírá místo v havárie v Hustopečích nad Bečvou — Karel III. zbavil svého bratra Andrewa zbývajících titulů — Prevence onkologických nemocí — Výjimečné tresty za vraždu — Žena naletěla podvodníkům a přišla o milion — Vznikající vláda chce znovu zavést EET — Návrat elektronické evidence tržeb — Zkušenosti živnostníků a podniků s EET — NSS o kampani SPD — Úklid a zdobení hrobů před Dušičkami — Kulturní akce spojené s dušičkami — Špatně osvětlení chodci a cyklisté — Zemřel generální ředitel Úřadu práce — Problémy německé ekonomiky — Přívalové deště v New Yorku — Fungování nového kruhového objezdu v Plzni — Izrael plní vysychající Galilejské jezero odsolenou vodou — Vražda ve věznici v Plzni — Uzavření Svijanské arény v Liberci — Oprava hodin na bazilice svaté Ludmily na Náměstí Míru

31. října
Znakový jazyk a skryté titulky

30. října
Headlines — Schůzka prezidentů USA a Číny — Trump a Si Ťin-pching se dohodli na obchodním příměří — Americko-čínské spory o čipy — Reakce na schůzku Trumpa s čínským prezidentem — Regulovaná složka cen elektřiny — Parlamentní volby v Nizozemsku — Předání ostatků rukojmích unesených Hamásem — Program nové vlády v oblasti školství — Obžaloba firmy AVE kvůli neodvádění poplatků — Vakcína proti žloutence — Model hlavního města se vrací do Muzea Prahy — Trump nařídil obnovit jaderné testy — Růst HDP ve 3. čtvrtletí r. 2025 — Krádeže informačních cedulí na Šumavě — Autobus naboural do domu v Benešově na Blanensku — Další zatčení kvůli loupeži v Louvru — Půl století od pádu jugoslávského letadla — Letecké nehody na území Československa — Záchranářské práce před 50 lety — Obvinění kvůli podvodům při získávání řidičských průkazů — Omezení imigrace do USA — Předpověď na další dny — Občanská válka v Súdánu — Rozhodnutí o demolici domova pro seniory v Meziboří — Následky hurikánu Melissa — NSS o výpadku služeb eDokladů během voleb — Výpadek vládních digitálních služeb — Ministr zahraničí v Izraeli — Polsko investuje do dálnic — Afghánec, který útočil v Aschaffenburgu, bude umístěn na neurčito na psychiatrii — Některé oblasti trápí sucho — Soud o výpověď ředitele Úřadu práce — České občanství pro potomky generále Vojcechovského

30. října
Znakový jazyk a skryté titulky

29. října
Headlines — Jednání o nové vládě — Dohoda na koaliční smlouvě — Jednání o programu vlády — Následky hurikánu Melissa — Nejsilnější hurikán v novodobé historii Jamajky — Vyšetřování loupeže v Louvru — Prevence rakoviny prsu — USA stahují část vojáků z Evropy — Boje na Ukrajině — Poslanec zvolený za ANO se mandátu neujme — Výzkumy oceněné Akademickou prémií — Hodnota společnosti Nvidia — Mrtví po izraelských útocích v Pásmu Gazy — Postup gruzínské vlády proti opozici — Pozastevení výroby v automobilce v Nošovicích — Desítky mrtvých po policejním zásahu v Riu de Janeiru — ČR s nejdražší elektřinou — Bourání staveb na sídlišti Jižní Svahy ve Zlíně — Nefunkční eDoklady — Začalo se oteplovat — Projev prezidenta — Předávání státních vyznamenání — Ocenění Řádem Bílého lva — Řád T. G. Masaryka — Ocenění medailí — Platy ve školství — Vraždění zdravotníků v súdánském Fáširu — Trump na návštěvě Jížní Koreje — Odstraňování mostu v Karlových Varech — Rozvoj komunitní energetiky — Volby v Nizozemsku — Spory o rekonstrukci skokanských můstků v Harrachově — Prodej zážitků před Halloweenem — Potkani lovící netopýry za letu — Memoáry Beatrice Landovské

29. října
Znakový jazyk a skryté titulky



